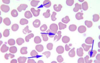
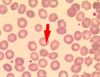
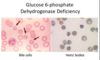
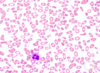

9 - Haemolytic Anaemias Flashcards
(30 cards)
What are some of the causes of haemolytic anaemia?

What are some of the symptoms associated with haemolytic anemias?
- Same as others e.g shortness of breath and fatigue
- Can have jaundice and gallstones due to bilirubin increase from hameolysis
What is microangiopathic haemolytic anaemia?
- Group of anaemias where red cells damaged by physical trauma, e.g trying to pass through small vessels laden with fibrin strands
- DIC, thrombotic thrombocytopenic purpura, HUS, defective heart valves, aortic valve stenosis
- Produces schistocytes
What are immune haemolytic anaemias?
- Can occur from infections, drugs like cephalosporins, or lymphoproliferative disorders
- Warm or cold

How do you test for immune haemolytic anameia?
- Direct Coombs test
- Red cells mixed with anti-human globulin antibody. If cells covered in antibodies, the anti-human globulin antibody will attach and make red cells clump together
- Suggests haemolysis is immune-related

Why does pyruvate kinase deficiency lead to haemolytic anaemia?
- PKLR gene mutation
- Can’t produce ATP so Na pump inhibited and red blood cells lose potassium
- Causes cells to shrink as they lose water and die
- Need regular blood transfusion
What would you view on a blood film of a pyruvate kinase deficiency and a G6PDH deficiency?

What should you do before starting a patient on drugs with known risk of haemolysis and oxidative damage?
- Test for G6PDH deficiency as a state of oxidative damage could lead to haemolytic crisis so jaundice and anaemia
What causes hereditary spherocytosis?
- Defect in one of 4 proteins
- Autosomal dominant or spontaneous mutation
- Release of microvesicles in unsupported membrane areas so reduction in membrane surface area so less deformable as SA lost

How is hereditary spherocytosis treated?
Splenectomy as spherocytes only seem to get trapped and damaged as they pass through the spleen
How do you test for hereditary spherocytosis?
- EMA binding test (Eosin-5-Maleimide)

What is infectious mononucleosis and how is it tested for?
- Glandular fever
- Viral infection common in children with little symptoms
- In young adults fever, sore throat, enlarged lymph nodes and liver/spleen can become enlarged
- Caused mainly by EBV and spread through saliva
- Paul Bunnell test (antibodies on patient’s serum)

What are the two types of haemoglobinopathies?
- Typically autosomal recessive
- Screening tests to detect
- Reduced rate of synthesis or synthesis of abnormal Hb

Where are the normal globin genes?
- Pair of beta on chromosome 11
- delta, gamma, alpha clumped singly on chromosome 16
- Usually under tight regulation so 1:1 ratio of alpha to non alpha chains

What are the different types of beta-thalassemia? (mutations not deletions)
- B thalassaemia minor: asymptomatic. usually microcytosis and no symptoms unless in times of increased demand like pregnancy
- B thalassaemia major: homozygous. dependent on blood tranfusions from several months old as HbA cannot replace HbF
(can have intermedia due to Bo and B+)
What are the different types of alpha thalassemia? (deletions/loss of function not mutations)
- Silent carrier: asymptomatic
- a-thalassemia trait: deletion of two genes. similar to b-thalassemia minor as microcytic and hypochromic
- HbH: deletion of three genes. severe anaemia, microcytosis, haemolysis, splenomegaly with target and heinz bodies
- Hydrops Fetalis: 4 genes deleted, not compatible with life

Why does thalassemia lead to haemolysis?
- Insoluble haemoglobin aggregates that get oxidised and damage teh red cell membrane.
- Hypochromic and microcytic

Who is more at risk of thalassemia?
- South asia,mediterranean, midle east (beta)
- Far east (alpha)
Offer couples prenatal counselling based on their ethnicity
What are the clinical similarities and differences between iron deficiency and b-thalassemia minor?
- Both microcytic and hypochromic
- Iron deficiency will have low Hb and anaemia but b-trait won’t
What are some of the clinical consequences of thalassemia?
- Extramedullary haemopoiesis (splenomegaly, hepatomegaly and bone cortex extension leading to bone deformities) due to high EPO
- Iron overload leading to premature death due to transfusions and increased iron absorption from diet

How do we treat thalassemia?
- Blood transfusions with iron chelation
- Immunisation (spleen overworked)
- Folic acid supplements
- Holistic care
- Stem Cell Transplant

What is sickle cell disease?
- Inheritance of sickle B-globin chain that has a point mutation leading to substitution of glutamate for valine in positon 6 of beta globin
- Mutation makes Hb more likely to polymerise at low oxygen tension
- HbSS homozygous sickle cell anaemia or HbS coinherited with HBC for example

Why does sickle cell disease lead to haemolytic anaemia?
- Usually mild as HbS gives up O2 more readily than HbA
- In low oxygen state the deoxygenated HbS forms polymers and forms a sickle. If this happens repeatedly leads to irreversibly sickled cells that are less deformable and can cause occlusions
- Recognised by spleen and removed

What are the consequences of sickle cell disease?
- Anaemia
- Jaundice and gallstones
- Splenic atrophy as splenic infarctions
- Vaso-occlusive episodes from cells getting trapped (acute chest syndrome, chronic kidney disease, joint damage)
- Priapism
- Stroke
- Kidney Failure